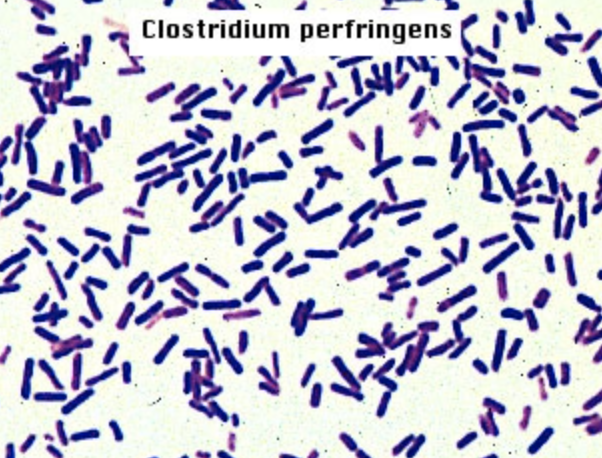

a spherical bacterium

coccus
rod-shaped bacteria
bascillus
a spiral-shaped bacterium

spirillum
visible mass of cells
colony
putting bacteria into a medium
innoculation
bacteria used in endospore staining

B.cereus
resting caused by lack of nutrients
endospore
- resistance to heat, radiation, acids & chemicals
- production of calcium dipicolinate
- cell dehydration
- spores can be destroyed in an autoclave
endospores
Differentiate between vegetative cells & endospores
endospore staining
protective protein coat of endospore
exosporium
endospore stain and coutnerstain
-malachite green
-counterstain: safranin
Waxy lipid, makes cells not permeable to most stains.
mycolic acid (acid fast)
primary stain in acid fast is
Carbolfuchsin
- stains acid-fast bacteria pink
Counterstain in acid-fast is
methylene blue
- stains non-acid-fast bacteria blue
decolorizer for acid fast staining
acid alcohol
bacteria used in acid-fast staining
mycobacterium smegmatis and stapholococcus
color of mycobacterium in acid fast stain
pink because they are acid fast
color of staph aureus in acid-fast stain
methylene blue bc they are non-acid fast
establish the difference between acid-fast & non-acid fast cells (differential stain)
acid-fast staining
- E.coli
- P.aeruginosa
- S.aureus
3 bacteria in the pure culture technique
- morphology
- arrangement
- internal structures
Good smears are important to observe
Two types of morphology
bacilli: rods
cocci: spherical
Two types of arrangements
staph: cluster
strep: chain
invented by christian gram to identify between bacteria and eukarya cells
gram staining













